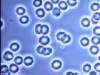
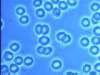
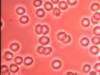

| 実体顕微鏡/品番 M249PS-R |
【詳細表示】
|
| 商品番号 |
M249PS-R |
価 格 |
 |
そのスペックは最新医療のために
●無断階デジタルズーム
●デジタル・ムービング・ビュー
●光学顕微鏡最大級 最大倍率1万1千倍(29インチモニター時)
●光源にはLED採用。環境に優しい超低消費電力 2.4W |
実体顕微鏡
品番 M249PS-R
定価 \550,000-
|
■特長
 |
やや平面的な画像でコントラストは位相差方式に劣るものの色彩は実物に近く再現されます。
赤血球を観察した場合、本来の赤い色で映し出されます。 |
| 血液 |
|
■機能
●無段階デジタルズーム
 |
◇広い視野で目標を見つけたらボタン一つでズームアップ。
◇ズーム倍率は無断階。
◇最大で通常倍率から面積比4倍のズームアップが可能。
最大総合倍率約 11,000倍。(29インチモニター時)
◇10ミクロンの細菌を約11cmの大きさで映像化。電子顕微鏡に迫る高倍率。
|
 |
 |
●デジタル・ムービング・ビュー
 |
◇「もう少しだけ右・・・」微動送りもデジタルで。
◇ズームアップしたまま、ボタンを押すだけで上下左右に視野を移動。
◇メカニカルステージでは不可能な超微妙な移動もワンタッチ。
◇粗動はメカニカル微動はデジタル使う人の身になって考えました。
|
 |
 |
 |
①ズームアップ&ダウン
②上下左右に視野を移動 |
|
■特色
●軽量・コンパクト
 |
ボディーサイズはスケジュール帳(A5)とほぼ同じ。 |
 |
|
 |
カバンにすっぽり収まるコンパクト設計。 |
●画像をテレビに映し出します
 |
①デジタル位相差顕微鏡本体
②ビデオケーブル(付属)
③ビデオ入力端子付テレビ
(付属しません)
④家庭用ビデオデッキ
(付属しません)
◇付属のケーブルでビデオ端子付きのテレビに接続して使用します
◇大きな画面で、一度に複数の人間が同時に観察できるので、非常に使い勝手がよく、特別な知識が無くても顕微鏡画像を観察する事が出来ます。
また、家庭用ビデオデッキで手軽に画像を記録できます。高価な専用機器を買い揃えなくても、ご家庭に有る電化製品で簡単に画像収録システムが構築できます。 |
●デジタル画像処理
「明るさ」「色合い」を手動調整することができます。もちろんフルオートで画質調整も可能。
 |
①色合い調整ツマミ
②明るさ調整ツマミ |
 |
ノーマル画像(フルオート) |
 |
「色合い調整ツマミ」を左へ |
 |
「色合い調整ツマミ」を右へ |
 |
「明るさ調整ツマミ」を左へ |
 |
「明るさ調整ツマミ」を右へ |
●最先端技術による設計・製造
 |
◇コンピューター解析による設計
パーツの細部にいたるまでコンピューター設計を採用。
光学系・力学設計共にバーチャルシュミレーションによって事前に問題点を洗い出し、完成度を高めています。 |
 |
◇中空アルミモノコック構造フレーム
他種顕微鏡に類を見ない構造は、高剛性と同時に軽量化も実現。
超軽量4.4kgを達成。 |
 |
◇インナースライド方式鏡筒
アウターパイプ内を、CCDカメラと対物レンズが一体となったインナーパイプがスライドする独自方式。超高倍率画像を安定させます。 |
|
■外形寸法図(単位㎜)
 |
A:346.9
B:160
C:130 |
|
■仕様
| 品番 |
M249PS-R |
使用可能
周囲温度範囲 |
+10~+30℃ |
分類
|
実体顕微鏡 |
| ステージ寸法 |
130×110㎜ |
| 内蔵カメラ |
1/4インチ40万画素CCDカメラ
オートホワイトバランス
無段階デジタルズーム
デジタル・ムービング・ビュー
|
| 出力 |
NTSC(ビデオ信号)準拠 |
| 光源 |
LED(高輝度発光ダイオード) |
| 集光 |
コンデンサーレンズ |
| 照準装置 |
内外筒(テレスコピック)方式
+
無回転ネジ送り(0.5㎜ピッチ) |
| 対物レンズ |
DIN ×40 0.65 |
| 総合倍率 |
<29インチモニター使用時>
通常時 5500倍
デジタルズーム使用時 11000倍 |
| 寸法 |
W130×D160×H346㎜ |
| 重量 |
4.4kg |
| 鏡筒長 |
191㎜ |
| 電源 |
AC100V
(専用ACアダプタ使用) |
| 消費電力 |
最大 2.4W |
*使用する1時間以上前から適正温度内に保ち、急激な温度の上昇・下降の無いようにして下さい。 |
■オプション
●USB接続ビデオキャプチャーケーブル
 |
オプションのキャプチャーケーブルを使用すれば、お手持ちのパソコンで画像観察や画像の収録・管理・編集が可能です。
品番 M249D-VS2
価格 \14,800- |
 |
●6インチ液晶モニターユニット
 |
超軽量6インチ
液晶モニター
持ち運びに便利な小型液晶モニター
本体にセットできるので場所を取らずとっても便利です。
品番 M249V-6
価格 \52,000- |
 |
本体上部に取り付け可能
正面・背面フリーレイアウト |
|